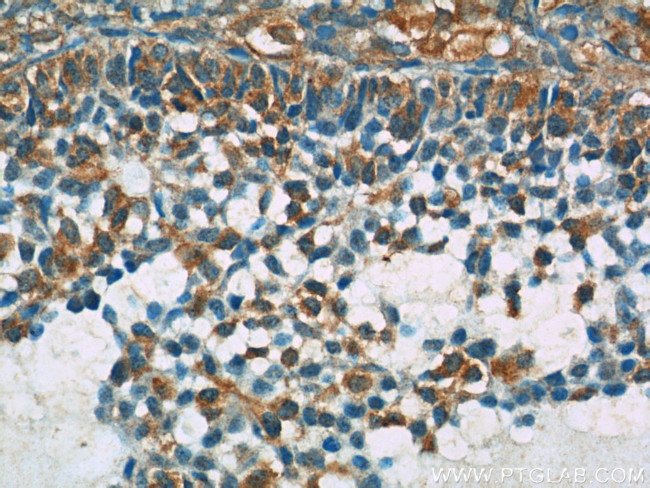
BIVM Antibody in Immunohistochemistry (Paraffin) (IHC (P))

Search
Proteintech
BIVM Polyclonal Antibody
{{$productOrderCtrl.translations['antibody.pdp.commerceCard.promotion.promotions']}}
{{$productOrderCtrl.translations['antibody.pdp.commerceCard.promotion.viewpromo']}}
{{$productOrderCtrl.translations['antibody.pdp.commerceCard.promotion.promocode']}}: {{promo.promoCode}} {{promo.promoTitle}} {{promo.promoDescription}}. {{$productOrderCtrl.translations['antibody.pdp.commerceCard.promotion.learnmore']}}
产品信息
25432-1-AP
种属反应
宿主/亚型
分类
类型
抗原
偶联物
形式
浓度
规格
纯化类型
保存液
内含物
保存条件
运输条件
产品详细信息
Immunogen sequence: LHCIIAFQR LNWQRFGLWN FPFGTIRQES QPPTHAQGIA KSESEDNISK KQHGRLGRSF SASFHQDSAW KKMSSIHERR NSGYQGYSDY DGND (411-503 aa encoded by B C075084)
靶标信息
BIVM has been identified using an electronic search based on the conservation of short sequence motifs within the variable region of immunoglobulin (Ig) genes. It is tightly linked (41 bp) and in the opposite transcriptional orientation to MGC5302 (also known as KDEL1 and EP58) in human. BIVM has two isoforms with MW 57 kDa and 32 kDa.
仅用于科研。不用于诊断过程。未经明确授权不得转售。
篇参考文献 (0)
生物信息学
蛋白别名: Basic immunoglobulin-like variable motif-containing protein; RP11-484I6.1; unnamed protein product
基因别名: BIVM
UniProt ID: (Human) Q86UB2
Entrez Gene ID: (Human) 54841